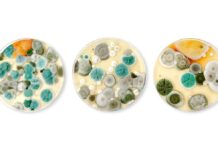

Зміст
На що приклеїти плінтус стельовий. Як приклеїти стельовий плінтус
На останньому етапі ремонтних робіт питання, як приклеїти стельовий плінтус вельми актуальне. Процес вимагає уважності і акуратності, інакше фрагменти відваляться, з’являться тріщини. З усіх відомих способів виділяють дві технології кріплення – з використанням шпаклівки і клею.
Як клеїти стельовий плінтус шпаклівкою
Метод підходить для ремонтних робіт, коли до фінішної обробки ще не приступали. Завдяки необробленої поверхні вдається домогтися кращого зчеплення. Поклейка стельового плінтуса на шпаклівку вважається найбільш простим способом.

Приступаючи до роботи, потрібно підготувати наступні матеріали:
Галтель. За допомогою шпаклівки можна прикріпити стельові багети практично будь-якого різновиду;
Шпаклівка. Суміш продають в звичайних будівельних магазинах, також можна скористатися залишками після ремонту. При виборі матеріалу враховуються два фактори: дата виготовлення і цілісність. Якщо шпаклівка втратила розсипчастість, то вона не придатна;
Грунт. Призначення складу-поліпшити якість зчеплення поверхонь. Краще використовувати грунт з глибоким проникненням.
Дізнаючись, як клеїти стельовий плінтус, можна зустріти рада – використовувати гіпсовий склад. Матеріал підходить, але він швидко схоплюється, що є великим недоліком, тому що не можна виправити дефекти, а наносити розчин і кріпити багет потрібно буде дуже швидко.
Щоб прикріпити галтелі на стелю шпаклівкою, потрібні наступні інструменти:
- ножівка по металу для підрізування. Якщо ширина багета близько 2 см, але не більше, застосовують канцелярський ніж. В іншому випадку якість плінтуса зіпсується.
- стусло для формування кутів.
- шпатель середньої довжини (8-10 см).
- наждачний папір. Вона потрібна, щоб надати гладкість поверхні галтелей, якщо вона виявиться шорсткою. Інакше приклеїти плінтуса буде складніше.
Щоб робота не затягувалася, попередньо набувають всі зазначені інструменти і матеріали. При поклейці декоративних планок більше важлива акуратність і точність, ніж великі пізнання в обробці.

Як клеїти стельовий плінтус:
- огляд місця, обраного для багета. Після нанесення фінішної обробки на поверхні нерідко з’являються дефекти. Їх усунення-завдання наждачного паперу, прикріпленої для зручності на брусок. Найкраще підготувати поверхню заздалегідь.
- обробка ґрунтовкою. Попередньо склад готується згідно з інструкцією виробника. Якщо використовується концентрат, його розбавляють. Грунтовка наноситься на повністю висохлий попередній шар.
- розмітка. Плінтус прикладається до місця майбутнього кріплення і по його краю проводиться лінія. Саме вона послужить орієнтиром.
- обрізка деталей. Використовуючи галтель з пінопласту, слід бути обережним – матеріал кришиться від неправильного впливу. Кути формуються стуслом. Рекомендується попередньо потренуватися.
- підготовка шпаклівки. Матеріал замішують безпосередньо перед початком виконання робіт. Тоді він не втратить властивостей. У ємність висипається суха суміш, яку розбавляють водою. Інструкція і пропорції компонентів вказуються виробником на упаковці. В результаті повинна вийти суміш без грудочок, досить густа.
- фіксація. На внутрішню сторону багета рівномірно наноситься обраний склад. Процедура виконується за допомогою шпателя. Важливо стежити, щоб суміш не потрапила на зовнішню сторону плінтуса. Не слід брати занадто багато розчину за один раз.
- установка. Багет прикріплюється до місця, зазначеного попередньо лінією. Не варто занадто сильно тиснути на плінтус. Якщо розчин свіжий, багет зафіксується швидко. Зайву суміш, що з’явилася з-під країв, негайно прибирають, поки вона не засохла.
Ідеальний клей для стельових плінтусів. Який клей краще?
До вибору клею для стельового плінтуса потрібно підходити уважно. Знаючи тип стельового плінтуса, який буде використовуватися для обробки приміщення, можна без проблем підібрати потрібний клей. Для кожного типу плінтусів використовується індивідуальний клей .
На
Поліуретан
Якщо для клейки поліуретанових галтелів використовувати звичайний клей, то вся робота буде марна. Незабаром галтелі відпадуть, що зажадає повторної роботи. Для такого виду плінтуса потрібно клей на полімерній основі , який схоплюється моментально і фіксує всі стики. Клей на полімерній основі можна замінити монтажним клеєм, клейовий шпаклівкою або стикувальним клеєм .
Пінопласт
Для цього виду плінтуса застосовуються рідкі цвяхи, шпаклівка або полімерні суміші , які міцно фіксують галтелі до поверхні. У нас також є окрема стаття, де докладніше розбирається питання про плінтусі з пінопласту .

Полістирол
Для полістирольних галтелів застосовується акрилова клейова шпаклівка, полімерні суміші, а також рідкі цвяхи .

Дерево
Існує 3 варіанти кріплення дерев’яних галтелів до поверхні:
Якірне або кліпсове кріплення;
кріплення за допомогою гвинтів або будівельних цвяхів;

кріплення за допомогою спеціального клеїться гнучкого елемента.
Пвх
Для цього типу плінтуса підходить практично будь-який клей. В окремій статті, ви можете почитати докладніше про види плінтуса .
Як клеїти стельовий плінтус на шпаклівку. Монтаж стельового плінтуса
Як же правильно організувати декоративну обробку за допомогою стельових плінтусів?
Перед тим, як приступити до виконання задуманої роботи, вам необхідно купити якісний стельовий плінтус з розрахунку, що одна стандартна планка має довжину два метри. Також при виборі правильної ширини галтелі необхідно враховувати висоту стель в будинку. Якщо у вас в будинку високі стелі, то добре підійдуть широкі плінтуса. Якщо ж висота вашої стелі-стандартна, наприклад, 2,80 метра, то відмінним варіантом буде галтель шириною 5 см.
Стельовий плінтус можна клеїти двома способами: із застосуванням шпаклівки і за допомогою акрилового герметика.
Багато професійних будівельників приходять до думки, що при виконанні ремонтних робіт перший варіант більш практичний, ніж другий. Особливістю першого варіанту є те, що немає необхідності робити демонтаж галтелі при зміні шпалер, а також досить зручно закладати щілини між плінтусом і стіною, особливо якщо є значні нерівності стін.
Розглянемо технологію наклейки стельових плінтусів за допомогою шпаклівки.
- за допомогою спеціального будівельного рівня і олівця необхідно зробити на стелі розмітку нижньої межі для установки плінтуса.
- замішайте фінішну шпаклівку в пропорціях, зазначених виробником. Після того, як ви замішали розчин і він став готовим до застосування, їм потрібно пройтися по місцях, де ви будете кріпити багет. Після цього необхідно змочити ґрунтовкою оброблені ділянки і приступати до приклеювання стельового плінтуса. Всі дії потрібно виконувати, поки поверхня стіни не висохла.
- за допомогою шпателя на зворотний бік стельового плінтуса густо нанесіть шпаклівку по всій довжині галтелі. Після цього потрібно притиснути плінтус до стелі і стіни, а виступила шпаклівку з стельового плінтуса видалити з допомогу шпателя.
- у тому випадку, якщо між стіною і плінтусом залишаються щілини, їх добре промазують шпаклівкою.
- після того, як фінішний розчин висох, обов’язково потрібно добре промазати їм всі наявні щілини, а також приховати місця стиків ділянок стельового плінтуса.
- після висихання шпаклівки можна приступати до виконання фарбування галтелі.
Як клеїти стельовий плінтус на криві стіни. Як правильно клеїти стельовий плінтус
Якщо перед поклейкою плінтуса не вирівняти стіни, не зробити ретельні прорахунки, можна отримати криво посаджений багет, погану стикування і відшарування елементів. Щоб цього не сталося, потрібно досконально вивчити інструкцію з монтажу.
Необхідні інструменти
- для порізки широких багетів потрібно приготувати ножівку по металу, вузькі конструкції до 2 см шириною можна відрізати канцелярським ножем.
- стусло, якщо є необхідність формувати куточки.
- неширокий шпатель.
- дрібнозерниста наждачка для шліфування шорстких поверхонь.
Підготовка поверхні
- оглядаєте стіни по периметру, в тих місцях, де планується закріплення бордюру. Усуваєте дефекти, вирівнюєте криві стіни. Особливо важливо зробити це ідеально, якщо буде використовуватися тонкийПлінтус. Шліфуєте стіни бруском, до якого прибивається дрібна наждачка.
- грунтуєте стіни і чекайте повного висихання поверхні.
- робите розмітку. Для цього прикладаєте окремі частини плінтуса на ті місця, де вони будуть фіксуватися. Відзначаєте стики олівцем. Ще до покупки багета можна накреслити приблизну схему його розташування на папері і розрахувати кількість елементів.
- вирізати деталі. Це найбільш відповідальний етап для початківців. Він може бути складним, якщо робота ведеться з пінопластовим бордюром, який кришиться, розсипається і може нерівно викроїтися. У таких плінтусах стики ріжуться прямо, а куточки під 45°. Краще попередньо попрактикуватися на дрібних шматочках.
Поклейка на шпаклювальну суміш
Поклейка стельової галтелі на шпаклівку робиться в кімнатах, де ще немає шпалер. Це забезпечує максимальну зчеплення з поверхнею.
Шпаклівка буває в готовому вигляді або у формі порошку, який повинен бути розсипчастим, без грудок. Професіонали можуть замінити шпаклювальну суміш гіпсовим складом, що володіє міцністю, але набагато швидше схоплюється. Для підвищення адгезійних властивостей можна додатково застосувати ґрунтовку глибокого проникнення і попередньо обробити нею поверхню перед поклейкою.
Зазвичай суха суміш засипається у відро, потім в неї вливають воду і вимішують міксером або вручну. Розводять суміш поступово, то підсипаючи шпаклівку, то підливаючи води.
Принцип роботи з уже готовою шпаклівкою :
- наберіть трохи розчину;
- тонким шаром нанесіть його на зворотну сторону багета;
- якщо лицьова сторона випадково забруднилася шпаклівкою, її треба почистити губкою або ганчіркою;
- встановлювати плінтус можна з будь-якого кута;
- елемент обережно притиснути до розміченому місцем і візуально оцінити установку;
- не варто сильно тиснути на плінтус, він і без зусиль зчепиться зі стіною;
- надлишки суміші відразу прибрати, але в разі нерівних стін, шпаклівку краще розподілити під краєм бордюру;
- приєднуючи наступний багет, потрібно попередньо змастити його торець шпаклівкою і тільки після цього приєднати до першого;
- таким же чином приклеїти всі елементи, залишити їх до повного висихання на добу;
- наносите клейовий склад на багет відповідно до ваги, розміру, матеріалом, з якого він виготовлений.
- рівномірно розподіляєте клей по плінтусу в центральній його частині, на яку припадає основний упор.
- прикладаєте багет до стіни, акуратно, але міцно натискаєте на конструкцію, утримуєте той час, що зазначено в інструкції клею.
- повторюєте ці ж дії по відношенню до інших деталей конструкції, акуратно поєднуючи розрізи деталей.
- ретельно промазуєте стики на торці, швидко прибираєте надлишки клею з боків і на лицьовій стороні.
Монтаж на клей
Поклейка виконується поверх шпалер, хоча на голих стінах також можлива.
Шпалери повинні бути поклеєні якісно, інакше багет може відпасти після монтажу разом з рулонами.
Якщо щілин багато або вони занадто великі, пофарбуйте плінтус білою фарбою, попередньо його прогрунтувавши. Фарба сховає вади або зробить їх менш помітними.
На що клеїти стельовий плінтус з поліуретану
Плінтус стельовий поліуретановий
Плінтус стельовий поліуретановий, властивості і характеристики якого роблять його сьогодні одним з найпопулярніших видів обробки.
Різноманіття зразків таких галтелів на ринку дозволяють підібрати плінтуси під будь-який вид обробки.
Властивості поліуретанових плінтусів
Багети з поліуретану мають ряд переваг перед іншими матеріалами.
Незважаючи на відносно невисоку вартість цього матеріалу, він володіємо рядом наступних позитивних якостей:
- поліуретан є одним з найбільш надійних і міцних матеріалів. Плінтуси з цього матеріалу вважаються навіть більш довговічними, ніж виготовлені з дерева.
- такі галтелі не деформуються під впливом температур, що робить їх практично універсальними: їх можна встановлювати у ванній кімнаті, на куні і в аналогічних місцях, де регулярно відбувається перепад температур.
Також плінтус з поліуретану не реагує на високу вологість і не вбирає неприємних запахів.
- з огляду на особливості матеріалу, ви зможете легко обробити плінтус таким чином, щоб він підходив до загального дизайну інтер’єру. Поліуретан можна фарбувати, створюючи будь-який орнамент або просто надаючи йому потрібний відтінок. Радять робити це акриловими фарбами: тоді поверхню плінтуса можна буде легко мити.
- якщо ви не дуже досвідчений майстер, то вибравши поліуретановий плінтус, ви зможете виконати його монтаж і установку досить просто.
Матеріал таких галтелів не кришиться при зарізуванні кутів, не ламається і відносно легко ріжеться навіть гострим ножем.
- для кріплення такого плінтуса підійде практично будь-яке клеїть речовина. Найчастіше використовують клей, рідкі цвяхи, або шпаклівку.
Шпаклівкою зручно обробляти і маскувати зазори, які часто утворюються на стику кутів.